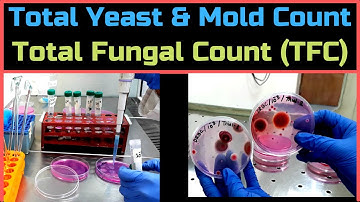
Total Yeast & Mold Count (Total Fungal Count)_A Complete Procedure (BAM, Ch-18)

⬇ DOWNLOAD NOW
Kalau muncul iklan pop-up, tutup lalu klik tombol kembali
Download lagu All about Isolation and identification of fungi (Molds) | MSc practical series | Microbiology secara gratis hanya untuk keperluan promosi. Dukung artis favorit kamu dengan membeli musik original di iTunes atau platform resmi lainnya.
 Introduction to Fungi
Introduction to Fungi
Total Yeast & Mold Count (Total Fungal Count)_A Complete Procedure (BAM, Ch-18)
Total Yeast & Mold Count (Total Fungal Count)_A Complete Procedure (BAM, Ch-18)
 Microbiology: Lactophenol Cotton Blue Technique
Microbiology: Lactophenol Cotton Blue Technique
 Techniques to study fungi | Mycology |Studying fungi/fungus | MSc Microbiology practical series
Techniques to study fungi | Mycology |Studying fungi/fungus | MSc Microbiology practical series
 Classification and Structure of Fungi (Fungal Infections - Lesson 1)
Classification and Structure of Fungi (Fungal Infections - Lesson 1)
 Microbiology: Mycology | Yeast and Mould
Microbiology: Mycology | Yeast and Mould
 A Guide to Isolating Pathogens
A Guide to Isolating Pathogens
 Isolation of Mesophiles with viva questions | Microbiology practical | MSc practical series
Isolation of Mesophiles with viva questions | Microbiology practical | MSc practical series